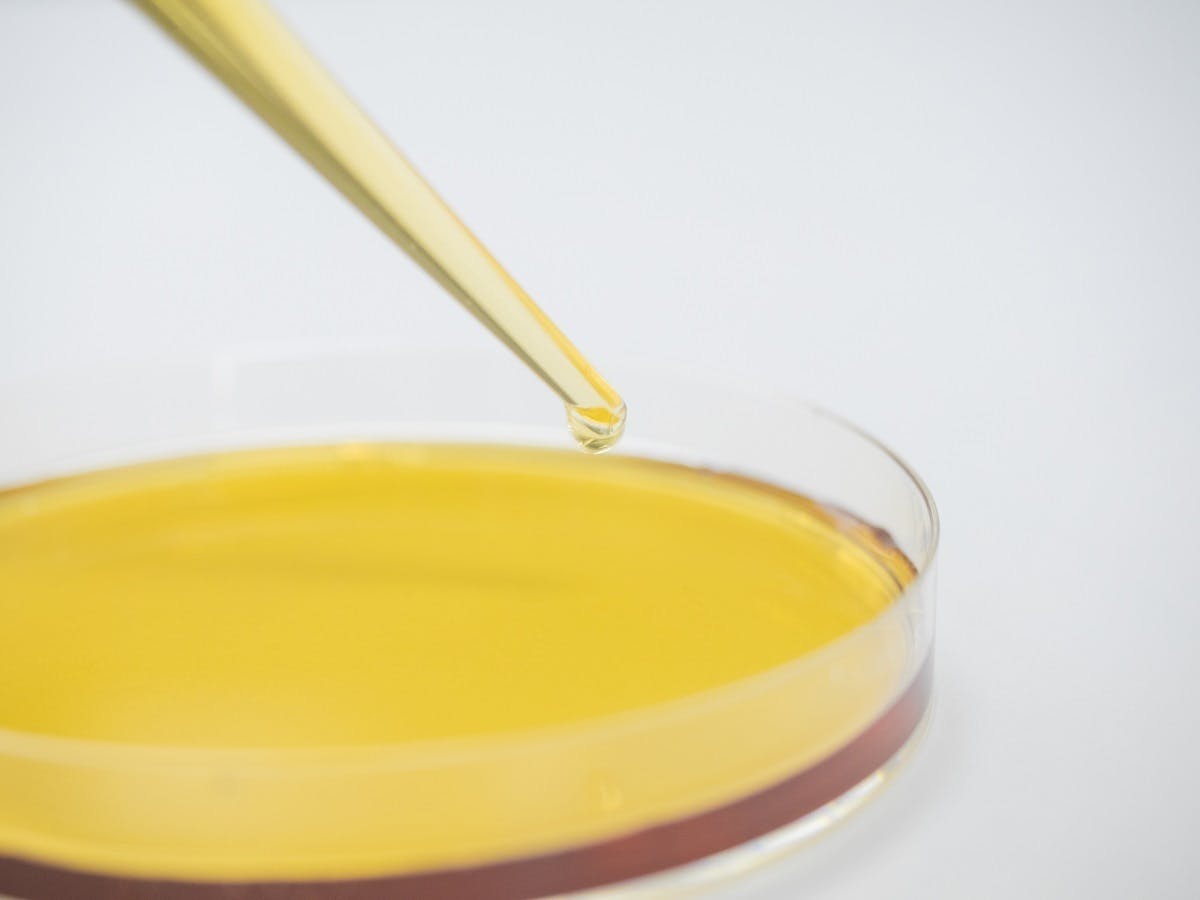

ご挨拶
はじめまして。USS by papawash(アス・バイ・パパウォッシュ)は、日用品を通して“ひとと地球の綺麗をめざす”ライフスタイルブランドです。
環境保全を第一に考え、サステナブルな世界の実現に取り組んでいます。
2022年2月に販売を開始する新スキンケア商品「USS ボトルエッセンス」は、美白作用のある画期的な新規美容成分“ヤナギタデ芽エキス”を配合。
この成分は福岡県朝倉市の特産農産物「紅タデ」から抽出されていますが、いま紅タデは持続的な生産活動の危機に面しています。

プロジェクトの目的
USS by papawashと、JA筑前あさくら紅タデ部会と共に立ち上げたこのプロジェクトでは、大きく2つの実現を目指します。
1.紅タデの存続と、長年培われた農業技術の継承
食品として利用されてきた紅タデですが、コロナ禍における飲食店営業自粛の影響で、需要が激減。日本の伝統食材を守るため、生産地を応援します。
朝倉の紅タデ農家
2.高機能植物紅タデの魅力を広める
免疫力を高め、健康によいたくさんのパワーを秘めた紅タデ。食品だけではなく、化粧品素材としての新たな高い機能性を実感いただき、一人でも多くの方に紅タデの魅力を知ってもらいたいです。
新スキンケア商品「USS ボトルエッセンス」
研究・開発を行うサティス製薬
プロジェクト立案のきっかけ
皆さんは、紅タデをご存知でしょうか?
お刺身のツマについてくる、紫色の小さな葉っぱ。あれが「紅タデ」です。
お刺身に添えられているのには理由があり、生ものの臭みや傷みを抑える機能があるのです。
高い抗酸化力や殺菌・抗菌作用を持つことから、日本では古くから解毒、虫よけ、下痢止めなどに使われてきました。
しかし現在は、生鮮食品の物流がスピーディーになったことで、抗菌を目的とした紅タデの利用は減少してきており、和食の彩りとしての活用に限られています。
そんな中、新型コロナウイルスの感染拡大により飲食店からの注文が激減。朝倉の紅タデ農家は、特殊な栽培法を採用していることから、すべてが紅タデだけを育てる専業農家。
今まさに持続的な生産活動に危機が迫っているのです。

「食以外の活用方法を見つけなければ、農家をはじめ、栽培技術まで失われてしまう……。」
そこで、私たちは紅タデに含まれるポリフェノールの一種「フラボノイド硫酸」に着目。
化粧品原料としての研究を行う中で、肌悩みを解決する新機能を発見し、2年の歳月をかけ今回商品化に至りました。
普段使うスキンケア商品を通して、「紅タデの効果を実感してほしい」「もっと魅力を広めたい」と強く思い、“紅タデの生産地を守るプロジェクト”を立ち上げました。
今だからこそ必要な紅タデ
町のシンボル、三連水車
福岡県の中南部、筑後川流域にある朝倉市。
水田地帯が広がり豊かな緑と水に囲まれた、どこか懐かしい風景が広がります。町のシンボルとして働く三連水車は、1760年代に建設されたといわれ、筑後川の豊かな水を運び続け朝倉の農業を支えています。
栄養をたっぷり含んだ水に育まれたこの肥沃な大地で、紅タデが生産されています。
朝倉の紅タデ栽培は30年以上続き、今では年間150万パックを全国に出荷する一大産地となりました。紅タデは普通に育てても紅色にならず、鮮やかな紅タデを生産するにはたいへんな手間がかかります。
専用の床作りから収穫までの繊細な一連の作業は、門外不出の技術になるほど。

「種をまく床作り、水やりの量やかけ方、すべてに気を付けなくては綺麗な紅色にはなりません。朝倉での紅タデ栽培は、常に品質向上を目指して生産を継続してきました。紅タデといえば刺身に添えられているもの、としか知られずその機能性を知らない人が多いと思います。しかし、免疫力を高める紅タデは、今こそ食べてほしい食材です。」(生産者:奥野さん)
新しい活用方法の模索

紅タデは、ヤナギタデの子葉。
もともとは日本各地の休耕地や川原に自生する植物で、水のなかで育つ湿性植物という種類に分類されます。
紅タデが含む「フラボノイド硫酸」は、ヤナギタデで初めて発見された成分。
この小さな小さな葉っぱの中に、たくさんの力を秘めており、化粧品原料としての活路を模索し研究を進める中で、驚くべき新たな機能が見つかったのです。
美容成分としての新機能の発見
紅タデは、水のなかで育つ植物。根からナトリウムイオンを吸収することで、植物の細胞内pHがアルカリ性に傾いてしまいます。pHバランスは生き物の生命活動を左右するとても重要なもの。
紅タデがもつフラボノイド硫酸は、細胞内のpHバランスを調整する役割を持ち、アルカリ性から酸性に戻す機能を担うと考えられています。
これを「細胞内酸性化作用」といい、紅タデは自らの働きで健やかな状態を維持しているのです。
pHにより左右されるのは、肌も同じ。
私たちの肌は、アルカリ性に傾くことで乾燥やニキビ、炎症などさまざまな肌トラブルを引き起こしやすくなります。健やかな肌を保つには、弱酸性に保つ必要があります。
今回は、紅タデのフラボノイド硫酸がもつ「細胞内酸性化作用」を応用して、美白のキーとなるチロシナーゼに作用することができないか研究を行いました。(※チロシナーゼ:メラニンをつくる際に働く肌内の酵素。過剰につくられたメラニンは、シミやくすみなど美容悩みの原因に。)

フラボノイド硫酸は、チロシナーゼが存在するメラノソーム内のpHに作用し、メラニン色素が作られにくくする作用が期待されます。このメカニズムは、従来のチロシナーゼに直接働きかける美白作用とは異なり、チロシナーゼを取り囲む環境へ働きかけるアプローチ方法。
こうして、肌の土台からメラニン生成を抑える「紅タデエキス」が完成したのです。

紅タデエキスをはじめ、清流が育んだ美容成分を豊富に配合して開発したのが、今回のスキンケア商品「USS ボトルエッセンス」。
メラニンをはじめ、毎日の生活の中で知らずしらずのうちに肌内に溜めてしまう不要なものをケアして、フレッシュで無垢な肌へ導く化粧水です。
製品のこだわり

活発に過ごす私たちの肌は、紫外線や汚れた空気にさらされ、気づかないうちに不要なものを肌に溜めてしまいがち。メラニンもそのひとつです。
USS ボトルエッセンスは、まるで美容液のような化粧水。

紅タデエキスをはじめとする植物由来のエキスが、汚れのない無垢な肌へ導きます。(※この製品は、上記紅タデエキスの効果効能を保証するものではありません。)
美容成分を豊富に抱え込んだとろんとしたエッセンスは、肌に触れた瞬間に美容成分がパシャっとあふれ出し、すーっと肌に染みわたります。使うたびにみずみずしく、フレッシュな肌感覚が得られます。

【こんな方におすすめ】
✔ 乾燥により肌全体がくすんだように感じる方
✔ べたべたとする感触が苦手な方
✔ みずみずしい感触のため、男性にもオススメ
容器は、天然水のボトルをイメージ。
再生プラスチックを使用し、プラスチックゴミの削減を目指しています。


その第一弾が「紅タデの生産地を守るクラウドファンディング」なのです。
支援金の使い道・スケジュール
■支援金の用途
皆さまから頂いた支援金は、
①本プロジェクトのリターン品調達 ②発送代金
を差し引いた残りすべての金額を
JA筑前あさくら紅タデ部会の活動費用や、種子購入費として活用させていただきます。
■スケジュール
1月11日~2月10日 クラウドファンディング実施
2月中旬〜 リターン品調達(乾燥紅タデの製造・その他リターン品調達)
2月末頃〜 リターン品の発送開始
リターン品のご紹介
美容成分たっぷりの化粧水「USS ボトルエッセンス」を気軽にお試しいただけるようなリターンをご用意しました。
また、朝倉の特産物セットを通して朝倉の伝統に触れていただきたいです。
(※一部抜粋)
・化粧水「USS ボトルエッセンス」
<早割>定価より50%OFF :2,000円〜
・化粧水、洗顔料の特別セット「USS by papawash スキンケアセット」
定価より28%OFF:5,000円
・USS ボトルエッセンス+朝倉の特産物セット(4種類):5,000円〜
・乾燥紅タデ+おすすめレシピシート:2,500円
紅タデをご家庭で食されたことが少ないのでは?と思い、今回リターン品としてご用意しています。
乾燥することで、生の紅タデより長期間保存が可能。ポリフェノールを多く含むので健康にもよいうえに、ポリフェノールの一種アントシアニンがすぐに溶け出し、鮮やかな紅色も体験いただけると思います。ぜひお楽しみください!
<全てクラウドファンディング限定/限定価格でのご用意です>
ぜひご支援いただき、紅タデと朝倉の魅力を体感していただきたいです。
他にもご用意しているので、詳細はリターンの掲載箇所をご覧ください。
※本プロジェクトはAll in方式で実施します。
目標金額に満たない場合も計画を実行し、リターンをお届けいたします。
実行者の紹介(五十音順)
●株式会社イー・エス・エス
1985年に設立し、36年間酵素洗顔を販売する化粧品会社。
USS by papawashは、2021年2月に新たに誕生したライフスタイルブランドです。ー私は、綺麗になりたい。でも、私が綺麗になるために、地球を汚すのはもう違うー
USS by papawashは、日用品を通して、ひとと地球がともに綺麗になる未来をめざし、水と海の環境保全に注力しています。第1弾製品の「USS by パパウォッシュバブル」は、海洋生分解性試験を行っている酵素洗顔料。すすいだ後の水にも責任を持ち、排水が海の環境に負担にならないことを確認しています。

USSブランドマネージャー:黒木
「綺麗な水がある風景を、もっとたくさん、もっと未来に残したい。そんな気持ちで、USSというブランドを通して活動しています。面白い機能をもつ植物も好きで、工夫を凝らして生き延びる彼らのことを、つい誰かに伝えたくなってしまいます。
今回は私の好きな「水」と「植物」をつなげて、人も地球も嬉しくなれることができるかもしれないと思い立ち、プロジェクトに至りました。商品をつくる過程で、私も初めて紅タデを知りました。知れば知るほど、愛らしさが増してくる植物です。みなさんにも、魅力が伝わりますように。」

USSボトルエッセンス開発者:笠原
「この商品は、”テクスチャー”と”効果実感”にとてもこだわって作りました。透明な外観の化粧水を肌に乗せた瞬間に、パシャッと弾ける体感。みずみずしい感触ですばやくなじむ浸透の速さ。肌のセラミドに類似した成分を用いることで、なめらかさも感じられます。 角層状態を改善する効果も。清流をイメージした感触を、ぜひお楽しみください。」
●株式会社サティス製薬
1999年に設立し、ナチュラルでありながら高機能な化粧品を製造する化粧品OEM会社。
国産の植物を用いて高機能な化粧品原料を開発し、ふるさとを活気づける「ふるさと元気プロジェクト」を実施。紅タデエキスは、2年の歳月をかけて開発した原料です。

紅タデ原料開発者:郡司
「私自身、化粧品原料開発に携わった今では紅タデが”添えてあるもの”から”体に良いから食べた方がよいもの”と見え方が大きく変わりました。日本伝統食材である紅タデが、人々の健康と美容に価値あるものと多くの人に知っていただき、これからも大切に受け継がれていくと嬉しいです。」
●JA筑前あさくら紅タデ部会
1985年に設立し、35年以上にわたり『博多本たで 四季紅』を出荷しつづけ、全国で70%以上のシェアを誇る。紅たでの機能性を活かし幅広い世代にPRし地域を元気づけようと活動しています。
タデ部会会長:奥野
「朝倉の肥沃な土壌で細部まで生産にこだわりをもって育てています。紅タデが皆様の健康や美容に役立つととてもうれしいです。」
JA筑前あさくら:伊藤
「紅タデには食べないのがもったいないほど、体によい成分がたくさん含まれています。生産者がこだわりをもって生産した紅タデが多くの人に届くことを願っています。」
最後に
紅タデはむしゃむしゃと大量に食べるようなものではなく、むしろ少量で高い機能を発揮することができる、とてもパワーのある植物です。ぜひ商品を通してその魅力に触れてみてください。
私たちは可能性を秘めた国産素材を製品化し、日本の伝統的な地域資源と自然環境を守っていきます。
紅タデ生産者、伝統生産技術を守るため、このプロジェクトを実現させたいです!
ぜひご支援をどうぞよろしくお願いいたします。
最後までご覧いただき本当にありがとうございました。
最新の活動報告
もっと見る年末イベント締切を11/30までに延長します!~希望者に特産品詰め合わせをお届けします~
2022/11/25 11:30本日締切としておりました年末イベントですが、多くの方にご希望をいただいております!そこで、参加締め切りを11月30日(水)23:59までに延長します!まだアンケートにご回答いただいていない方は、是非ご参加ください。年末イベントのご案内2022年度実施したプロジェクト、3つの地域に関わる産品詰め合わせセットを、ご希望のみなさまにお届け致します。詳細は以下をご確認ください。<詳細>以下アンケートより特産品の配送希望いただいた支援者様全員に、産品詰め合わせセットを送付致します。■Googleフォームよりアンケートにご回答ください。https://docs.google.com/forms/d/1qdlhRt5RZuJbQqgX1Pl5A_gzQBrL7hgLJ7S-3RhRsXM/edit※アンケート回答締め切:2022.11.30(水)23:59まで※特産品配送のご希望は、アンケート内でご回答いただけます。発送予定日:2022年12月16日(金) ※発送日は前後する可能性がございます。※産品詰め合わせの内容はご指定いただくことが出来ません。予めご了承ください。つなぐキレイマルシェ もっと見る
特産品詰め合わせセットをお届けします ~年末イベントのお知らせ~
2022/11/18 16:352022年度実施しましたクラウドファンディングへのご支援、ありがとうございました。ご支援いただいたプロジェクトは、「つなぐキレイマルシェ」というキュレーション(まとめ)サイトでも公開をしておりました。「つなぐキレイマルシェ」はあなたの肌を綺麗にする行動(お買い物やご支援)が、ふるさとの伝統や景色、そこにしかない素材(天然物)を守ることや、地球のキレイにつながる。そんなプロジェクトを集めたサイトです。※URL:https://camp-fire.jp/curations/tsunagukireimarche2022年度は、実施した3プロジェクトすべて支援金額目標を達成をすることが出来ました!産地の素敵な商品や化粧品、国産素材の魅力をお届け出来たことが嬉しく、ふるさとを思う方がこんなにも多いことを実感し、温かい気持ちになりました。「つなぐキレイマルシェ」より、年末イベントのご案内2022年度実施したプロジェクト、3つの地域に関わる産品詰め合わせセットを、みなさまにお届け致します。詳細は以下をご確認ください。<詳細>以下アンケートより特産品の配送希望いただいた支援者様全員に、産品詰め合わせセットを送付致します。■Googleフォームよりアンケートにご回答ください。https://docs.google.com/forms/d/1qdlhRt5RZuJbQqgX1Pl5A_gzQBrL7hgLJ7S-3RhRsXM/edit※アンケート回答締め切:2022.11.25(金) 23:59まで※特産品配送のご希望は、アンケート内でご回答いただけます。発送予定日:2022年12月16日(金) ※発送日は前後する可能性がございます。※産品詰め合わせの内容はご指定いただくことが出来ません。予めご了承ください。2023年も「つなぐキレイマルシェ」は、様々な地域の特産品を応援し、あなたの肌を綺麗にする化粧品を世の中に生み出し広める活動して参ります。今後ともよろしくお願い致します。つなぐキレイマルシェ もっと見る
いただいた支援金を、紅タデ種子購入資金として活用いただきました!
2022/04/28 15:09こんにちは。お久しぶりでございます!USS by papawashの黒木です。みなさま、お変わりなくお過ごしでしょうか?本日は、みなさまからいただいたご支援金を、4月上旬に無事にJA筑前あさくら紅たで部会さまへお渡ししたことをご報告いたします!そして、紅タデ種子購入資金としてご活用いただけました!!紅タデ種子と紅タデの種子。私も初めて見ました…!!紅たで部会 部会長の鳥居さま、副部会長の奥野さま、JAご担当の伊藤さまより、心のこもったお手紙もいただいております。お手紙の一部をご紹介いたします。~抜粋~この度は紅たでの機能性に着目して頂き、紅たでを使用したスキンケア用品の商品化により産地支援ありがとうございました。コロナにより厳しい販売環境の中で、今回のように「食」以外でのたでの使用は長年の課題であったため、生産者一同喜んでおります。(中略)初めてクラウドファンディングに参加させて頂き、多くの方に紅たでの存在を知っていただく結果になったことはうれしく思います。この度は心よりお礼申し上げます。~~~紅たでを化粧品に利用する取組みは、取引業者の方にとって大きなインパクトとなったようです。紅たでの機能性を改めて勧めやすくなった、というお言葉もいただきました。今回の生産支援プロジェクトは、ご支援いただいた皆さまなしには叶いませんでした。本当に、ありがとうございました!これからも心の片隅に、紅タデを住まわせていただければ嬉しく思います。 もっと見る






コメント
もっと見る